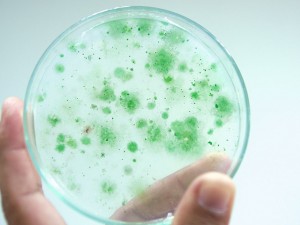
Clinical microbiology

Showing 1 to 2 of 2 (1 Pages)
Arkan Labs Blog - Culture Media
Arkanlabs is a global leader in the sales of refurbished analytical equipment, headquartered in Saudi Arabia. We sell new equipment for laboratory and medical, chemicals, and much more, with over 15,000 unique products to fit all the needs of your lab. We supply solutions, reagents, kits, cell lines, furniture, glassware, biotech goods, and all other important laboratory supplies and laboratory equipment and Medical Equipment's and supplies in Saudi Arabia and overseas for research in genomics, proteomics, microbiology, chemistry, molecular biology, cell culture, and other fields.









-50x50h.jpg)